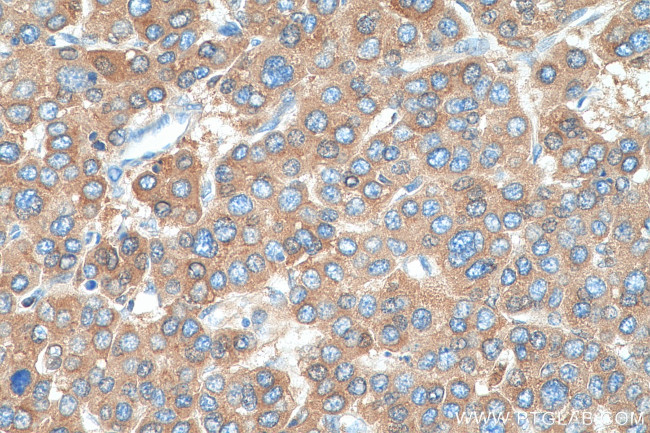
C3/C3b/C3c Antibody in Immunohistochemistry (Paraffin) (IHC (P))

Search
Proteintech
C3/C3b/C3c Polyclonal Antibody
{{$productOrderCtrl.translations['antibody.pdp.commerceCard.promotion.promotions']}}
{{$productOrderCtrl.translations['antibody.pdp.commerceCard.promotion.viewpromo']}}
{{$productOrderCtrl.translations['antibody.pdp.commerceCard.promotion.promocode']}}: {{promo.promoCode}} {{promo.promoTitle}} {{promo.promoDescription}}. {{$productOrderCtrl.translations['antibody.pdp.commerceCard.promotion.learnmore']}}
产品信息
21337-1-AP
种属反应
已发表种属
宿主/亚型
分类
类型
抗原
偶联物
形式
浓度
规格
纯化类型
保存液
内含物
保存条件
运输条件
产品详细信息
This antibody raised against 1314-1663 aa of human C3 protein recognize C3 alpha chain, C3b alpha' chain, and C3c alpha' chain fragment 2.
Immunogen sequence: ESASLLRSE ETKENEGFTV TAEGKGQGTL SVVTMYHAKA KDQLTCNKFD LKVTIKPAPE TEKRPQDAKN TMILEICTRY RGDQDATMSI LDISMMTGFA PDTDDLKQLA NGVDRYISKY ELDKAFSDRN TLIIYLDKVS HSEDDCLAFK VHQYFNVELI QPGAVKVYAY YNLEESCTRF YHPEKEDGKL NKLCRDELCR CAEENCFIQK SDDKVTLEER LDKACEPGVD YVYKTRLVKV QLSNDFDEYI MAIEQTIKSG SDEVQVGQQR TFISPIKCRE ALKLEEKKHY LMWGLSSDFW GEKPNLSYII GKDTWVEHWP EEDECQDEEN QKQCQDLGAF TESMVVFGCP N (1314-1663 aa encoded by BC150179)
靶标信息
Complement component C3 plays a central role in the activation of complement system. Its activation is required for both classical and alternative complement activation pathways. People with C3 deficiency are susceptible to bacterial infection.
仅用于科研。不用于诊断过程。未经明确授权不得转售。
生物信息学
蛋白别名: acylation-stimulating protein cleavage product; C3 and PZP-like alpha-2-macroglobulin domain-containing protein 1; C3a anaphylatoxin; Complement C3; complement component 3; complement component C3a; complement component C3b; epididymis secretory sperm binding protein Li 62p; HSE-MSF; prepro-C3; unnamed protein product
基因别名: AHUS5; AI255234; ARMD9; ASP; C3; C3a; C3b; CPAMD1; HEL-S-62p; HSE-MSF; Plp
UniProt ID: (Human) P01024, (Rat) P01026, (Mouse) P01027
Entrez Gene ID: (Human) 718, (Rat) 24232, (Mouse) 12266